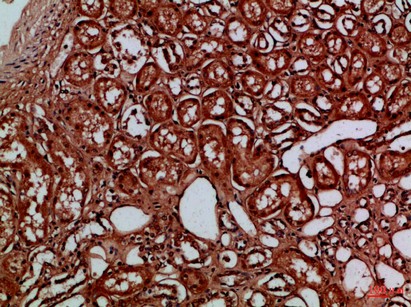

-
Product Name
Anti-EYA1 antibody
- Documents
-
Description
Rabbit polyclonal antibody to EYA1
-
Tested applications
IHC-P
-
Species reactivity
Human, Mouse
-
Alternative names
BOP antibody; BOR antibody; BOS1 antibody; OFC1 antibody
-
Isotype
Rabbit IgG
-
Preparation
This antigen of this antibody was synthetic peptide from human protein at aa range: 271-320
-
Clonality
Polyclonal
-
Formulation
Liquid, Liquid in PBS containing 50% glycerol, 0.5% BSA and 0.02% sodium azide.
-
Storage instructions
Store at +4℃ after thawing. Aliquot store at -20℃ or -80℃. Avoid repeated freeze / thaw cycles.
-
Applications
IHC-P: 1:50-200
-
Validations
Fig1:; Immunohistochemical analysis of paraffin-embedded Human-kidney, antibody was diluted at 1:100
- Background
Related Products / Services
Please note: All products are "FOR RESEARCH USE ONLY AND ARE NOT INTENDED FOR DIAGNOSTIC OR THERAPEUTIC USE"
